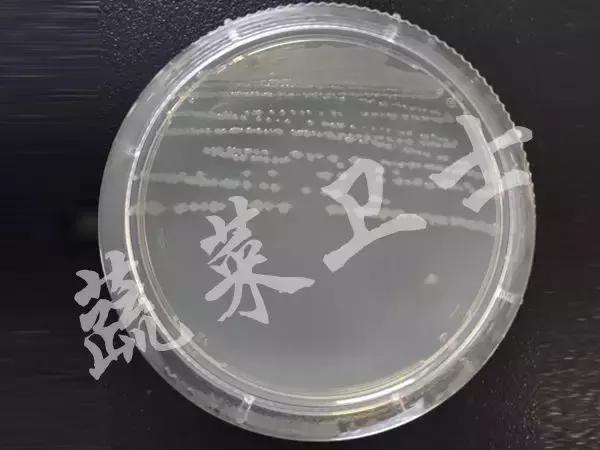
番茄专治机油病,番茄苗期得机油病
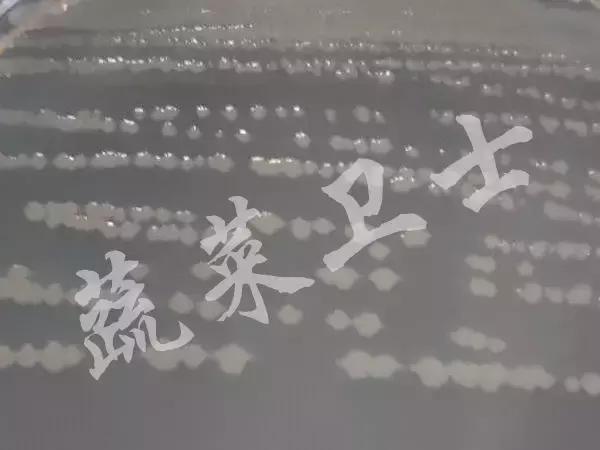
番茄专治机油病,番茄苗期得机油病

【病虫播报】番茄“机油病”大爆发,如何有效防控?
1、番茄“机油病”大爆发,如何有效防控?
(1)番茄细菌性斑点病发生严重,大家要提高警惕!
近期,通过我们调查发现,全国多地番茄出现了一种症状,叶片上出现黑褐色斑点,随着病情扩展病斑连接成片造成叶片腐烂,茎秆和果实上也会出现类似的症状,结合田间症状和检测后诊断该病是细菌性斑点病,又称“机油病”。

番茄细菌性斑点是番茄上近年来危害非常严重的一种病害,一般情况下可减产 10%~30%,严重地块减产50% 以上,需要引起我们的高度重视,下面我们就将症状诊断、病原菌、防控措施等介绍如下,希望对大家有所帮助。更多蔬菜病虫害相关资讯请搜索并关注蔬菜卫士公众号(shucaiweishi)
(2)番茄细菌性斑点病,准确识别很关键!
田间症状:番茄细菌性斑点病可危害叶片、茎秆、果实等,叶片感病初期产生深褐至黑色不规则斑点,斑点周围有或无黄色晕圈,后期连接成片;茎秆感病,初期产生黑色斑点,后逐渐扩大,病斑易连成斑块,严重时可使一段茎部变黑;果实感病,会产生黑褐色斑点,病斑周围黑色,中间色浅并有轻微凹陷。

叶片发病症状

茎秆发病症状

果实发病症状
病原菌:引起番茄细菌性斑点病的病原菌为丁香假单胞杆菌番茄致病变种(Pseudomonas sringae pv. tomato)该病原菌革兰氏染色为阴性,无荚膜,无芽孢;菌体杆状,直立或稍弯,大小为(0.5~1.0)μm×(1.5~5.0)μm,单细胞,有 1 至数根鞭毛,在 NA 培养基上形成乳白色圆形菌落。

NA培养基上的菌落形态
(3)番茄细菌性斑点病为何发生如此严重?
①初侵染来源广泛
病菌可在番茄植株、种子、病残体、土壤或杂草上越冬,成为翌年的初侵染源,其中种子带菌是最主要的初侵染源,病原菌可随种子远距离传播,种子带菌后,幼苗即可发病。
②棚室内温湿度环境,适宜病原菌的传播和侵染
番茄细菌性斑点病为适温高湿病害,在25℃以下的温度和80%以上的相对湿度,有利于发病,因此冬春保护地番茄往往受害较重。
③栽培措施不当
病原菌可通过雨水、昆虫、农事操作等进行传播,尤其是当遭遇低温阴雨天气和低洼、排水不畅的地块容易造成病害的发生和流行。同时,当田间发病后,没有及时清除病残植株,也是病害大爆发的重要影响因素。
(4)番茄细菌性斑点病到底应该如何防控?
①减少初侵染来源
减少初侵染来源是防控该病的有效手段,在上茬结束后,我们要彻底清除田园,在夏季休棚期,有条件的地方可以使用石灰氮、威百亩等土壤消毒剂结合太阳能进行高温闷棚处理,能够有效减少田间的各种病原菌。在播种前要进行种子消毒处理,可以使用55℃的温汤浸种30分钟,也可以使用3%中生菌素可湿性粉剂600~800倍液浸种30分钟,洗净后进行播种。
②加强田间管理
严格控制棚内或田间的湿度;田间湿度大时,尽量避免进行整枝、打杈等农事操作;田间发现病株,应立即清除,并在田外进行深埋,减少翌年的初侵染源。
③及时用药防治
发病初期及时施药,可选用 77%氢氧化铜可湿性粉剂 800倍液,或 2%春雷霉素水剂600~800倍液,或3%中生菌素可湿性粉剂500倍液等药剂进行轮换使用,在田间湿度较大时,可以使用精量电动弥粉机配合格瑞微粉5号进行喷粉防治,在不增加田间湿度的情况下,能够取得更好的防治效果。
“番茄‘机油病’大爆发,如何有效防控?”由国家重点研发计划项目:“设施蔬菜化肥农药减施增效技术集成研究与示范”提供技术支持
2、苦瓜叶片出现大面积坏死斑,原来是“它”在搞鬼!
近期,来自云南玉溪种植户非常苦恼,他种植的苦瓜叶片上出现了大面积的坏死斑,严重影响着苦瓜的产量和品质,紧急在蔬菜卫士平台上进行求助,下面我们就来看一下具体图片。
从图片上来看,苦瓜叶片正背两面上形成近圆形或不规则形病斑,中央灰白色或灰褐色,边缘深褐色,稍有轮纹,经过我们专家和群友诊断,这是尾孢叶斑病的危害症状。

尾孢叶斑病是苦瓜上的一种常见病害,在降雨多、湿度高的环境条件下发病严重,所以为防控该病的发生,首先要彻底清除田园,减少初侵染来源;其次要加强田间管理,注意雨后及时排水,避免田间湿度过大;最后,在发病初期及时用药防治,可以选用苯醚甲环唑、异菌脲、嘧菌酯等药剂进行轮换使用,才能够取得较好的防治效果。 更多蔬菜病虫害相关资讯请搜索并关注蔬菜卫士公众号(shucaiweishi)
3、你真的认识花椰菜霜霉病吗?
霜霉病是蔬菜上一种常发病害,我们通常的印象一般是黄瓜叶片正面出现黄色受叶脉限制的褪绿斑,背面出现灰褐色霉层,其实霜霉病的发病症状是多种多样的,近期在江苏南通就发生了霜霉病,下面我们就具体来认识一下。
花椰菜霜霉病发生时,叶片正面产生较小的褪绿斑,随着病情发展,病斑中央变为灰褐色,然后逐渐扩大,当湿度较大时,病斑背面会产生稀疏状白色霉层,后期病斑连接成片,导致叶片坏死。

霜霉病的防控首先要做好预防,通过前期的水肥管理、合理密植等措施来控制田间湿度不要过大和培育健壮植株。其次,要准确识别症状,加强巡查,发生初期及时用药防治,药剂可选用烯酰吗啉、氰霜唑、氟菌·霜霉威等药剂,注意药剂的轮换使用,避免抗药性的产生。
4、顽固的蔓枯病,到底应该如何防控?
蔓枯病是近年来瓜类上发生比较严重一种顽固病害,尤其是冬春季节,低温寡照的环境条件为该病的发生创造了有利条件,所以该病在近期发生非常普遍和严重。其中,山东聊城的群友就遇到了这个问题,从图片中我们可以看出,茎蔓分枝或近节处有琥珀色胶状物,病斑纵向蔓延,这就是比较典型的蔓枯病的危害症状。

蔓枯病是一种高湿病害,所以为防止该病的发生,首先要对土壤进行消毒处理,在夏季休棚期,可利用高温闷棚进行土壤消毒,以减少初侵染来源;其次,要加强栽培管理,施用充分腐熟的有机肥,增施磷钾肥,培育健壮植株,使用高垄栽培,适时通风排湿,使用膜下滴灌或暗灌,科学通风,控制田间湿度;最后要及时用药,药剂可选用嘧菌酯、啶氧菌酯、氟菌·肟菌酯进行喷雾防治,对于发病严重的茎蔓,可用上述药剂配成一定浓度的药剂,用毛笔对发病部分进行涂抹,具有一定的防治效果。
5、灰霉病强势来袭,防控刻不容缓!
灰霉病是近年来番茄设施蔬菜栽培的主要病害,该病原菌可侵染番茄叶、茎、花、果实等不同部位,发病后传播速度快,一旦发生就很难防治,严重时会造成严重损失。
近期,山东烟台种植户的番茄发生了灰霉病,从图片中我们可以清楚的看到灰霉病从番茄残留花瓣处侵染,引起萼片及果蒂部发病,出现灰褐色病斑,从萼片部向四周发展,造成果实腐烂,可产生灰色霉层。

灰霉病是一种低温高湿病害,一般从作物的残花或腐败处开始侵染,所以为防止该病的发生,首先要加强田间管理,通过棚室保温、膜下暗灌、加强通风等措施,来提高棚内温度和降低田间湿度来创造不利于病害发生的条件。其次,要注意提前预防,尤其是在花期提前喷施药剂和残花要及时摘除;最后,要科学用药,在发病初期,及时将发病残花、果实等带出棚外,然后喷施药剂,可选用腐霉利、啶酰菌胺、氟菌·肟菌酯等药剂进行轮换使用,能够取得较好的防治效果。更多蔬菜病虫害相关资讯请搜索并关注蔬菜卫士公众号(shucaiweishi)
声明
未经授权,不得转载。
如有需要,请联系授权(shucaiweishi@163.com)。